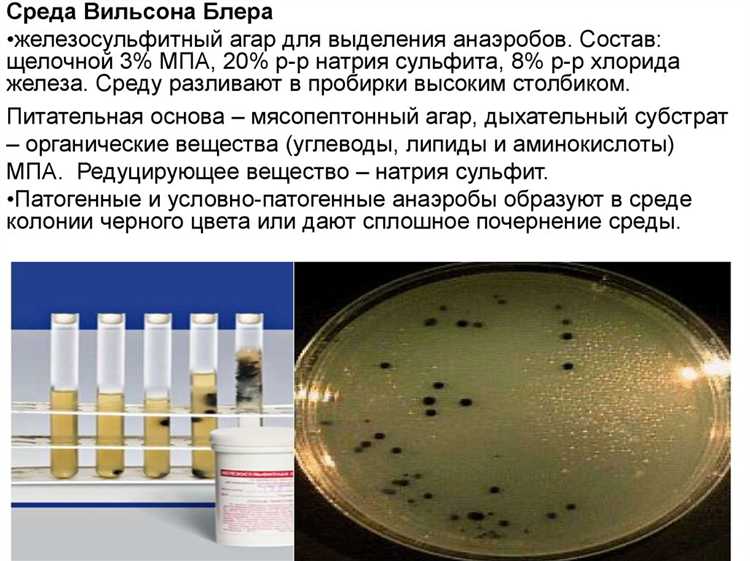
Температурные условия и их роль в восстановлении микрофлоры Биозоны

Восстановление микробиологического баланса в Биозоне после временного отключения оборудования занимает от 48 до 72 часов при оптимальных условиях. Ключевой фактор – поддержание стабильной температуры в пределах 22–25 °C и влажности около 60%. Резкие колебания окружающей среды могут увеличить время регенерации до недели.
Активность бактерий восстанавливается поэтапно: сначала возобновляется метаболизм аэробных штаммов, затем происходит рост анаэробных колоний. Уже через 24 часа после включения биореактора фиксируется восстановление до 60% исходной биомассы. Полное возвращение функциональной активности достигается на третьи сутки при регулярном мониторинге параметров среды.
Рекомендуется исключить добавление новых питательных сред в течение первых 12 часов после запуска для снижения стрессовой нагрузки на микрофлору. Также важно обеспечить стабильный аэрационный режим и минимизировать механические воздействия на субстрат. Такие меры существенно сокращают время адаптации и улучшают восстановительный потенциал бактерий.
Влияние длительности отключения на скорость регенерации бактерий

Продолжительность отключения систем Биозоны напрямую влияет на скорость восстановления бактериальной микрофлоры. При коротких перерывах до 2 часов регенерация происходит в течение 4–6 часов, что обеспечивает сохранение функциональной активности биокультуры без снижения эффективности очистки воздуха.
Отключения продолжительностью от 2 до 6 часов приводят к снижению концентрации активных бактерий на 30–50%. В этом случае полный цикл восстановления занимает от 12 до 18 часов. При таких условиях рекомендуется запускать систему на полную мощность сразу после включения для ускорения размножения бактерий.
При перерывах свыше 6 часов численность жизнеспособных микроорганизмов снижается более чем на 70%. Регенерация затягивается до 24–36 часов, что может негативно сказаться на качестве очистки и требует дополнительных мер, например, повторного посева или обновления биокультуры.
Для минимизации времени восстановления после длительных отключений следует проводить профилактическую активацию бактерий с помощью специальных субстратов, стимулирующих рост микрофлоры. Регулярный мониторинг концентрации бактерий в Биозоне позволяет оперативно корректировать режимы работы и снижать риски длительной регенерации.
Температурные условия и их роль в восстановлении микрофлоры Биозоны
Оптимальная температура для восстановления микрофлоры Биозоны варьируется в диапазоне 22–28°C. При температуре ниже 18°C активность бактерий снижается, что удлиняет период восстановления на 30–50%. При превышении 30°C риск подавления полезных штаммов увеличивается из-за ускоренного метаболизма и возможного выброса токсинов.
Для ускорения восстановления рекомендуется поддерживать стабильный температурный режим с отклонениями не более ±1°C. Резкие перепады выше 5°C приводят к стрессу микрофлоры и увеличивают время регенерации минимум на 20%. Важна равномерность прогрева, исключающая локальные зоны переохлаждения или перегрева.
Использование автоматических систем контроля температуры позволяет снизить человеческий фактор и обеспечивает постоянство условий. В периоды отключения электричества и возобновления работы Биозоны критически важно проверить температурный режим в первые 12 часов, так как именно в этот промежуток формируется начальный состав микрофлоры.
Рекомендуется дополнительно использовать пассивные теплоизоляционные материалы для снижения теплопотерь и поддержания микроклимата. В случае невозможности соблюдения температурного диапазона, целесообразно применять адаптивные бактерицидные культуры, устойчивые к низким или высоким температурам, что сокращает период восстановления на 15–25%.
Значение влажности воздуха для активации бактерий после простоя

Оптимальный уровень влажности для ускоренного запуска биологических процессов находится в диапазоне 60–75%. В таких условиях бактерии восстанавливают жизнедеятельность в среднем за 4–6 часов, в то время как при влажности ниже 50% этот срок увеличивается до 12 и более часов.
Рекомендуется использовать системы увлажнения воздуха с точностью регулировки ±3%, чтобы поддерживать стабильный микроклимат. Резкие колебания влажности вызывают стресс у микробных сообществ и снижают эффективность их работы.
При повторных простоях или длительном отключении важно предварительно повысить влажность воздуха за 1–2 часа до включения Биозоны. Это создаст благоприятные условия для активации бактерий и ускорит восстановление биологических функций.
Ключевые параметры для контроля: относительная влажность 60–75%, стабильность ±3%, предварительный этап увлажнения перед запуском. Игнорирование этих условий приводит к значительному увеличению времени восстановления и снижению общей эффективности системы.
Методы контроля и мониторинга восстановления бактериальной среды

Для эффективного восстановления бактериальной среды в Биозоне после отключения применяют комплексные методы контроля и мониторинга, ориентированные на количественную и качественную оценку микробиологической активности.
-
Регулярный микробиологический анализ проб воздуха и поверхностей
- Посевные методы с использованием селективных питательных сред для выделения ключевых бактерий.
- Подсчет колониеобразующих единиц (КОЕ) для определения концентрации жизнеспособных микроорганизмов.
- Использование дифференциальных сред для выявления изменений в составе микрофлоры.
-
Методы молекулярной биологии
- ПЦР-анализ для выявления специфических генов бактериальных штаммов, отвечающих за биологические функции в Биозоне.
- Метагеномное секвенирование для комплексной оценки видового состава и функционального потенциала микробиоты.
-
Измерение биохимической активности
- Определение уровня ферментативной активности (например, дегидрогеназ, фосфатаз) в пробах для оценки жизнеспособности и метаболизма бактерий.
- Измерение продукции биогазов (CO2, H2S) как индикатора метаболической активности.
-
Автоматизированные системы мониторинга
- Использование биосенсорных приборов, фиксирующих изменения параметров среды в режиме реального времени.
- Интеграция данных с системой управления Биозоной для оперативного анализа и корректировки условий восстановления.
-
Частота мониторинга
- Первые 48 часов после отключения – анализ каждые 6 часов.
- На протяжении первой недели – ежедневный контроль.
- Далее – мониторинг 2 раза в неделю до стабилизации показателей.
Соблюдение указанного протокола позволяет обеспечить своевременное обнаружение отклонений в составе и активности бактериальной среды, а также принять меры для ускорения восстановления и стабилизации биологических процессов в Биозоне.
Рекомендации по оптимизации условий для ускоренного восстановления бактерий
Для ускорения восстановления бактериальной популяции в Биозоне после отключения необходимо обеспечить стабильный температурный режим в диапазоне 22–26 °C. При снижении температуры ниже 20 °C активность бактерий падает на 30–40%, что удлиняет время восстановления до 48 часов.
Поддержание влажности воздуха на уровне 60–70% способствует улучшению метаболической активности бактерий. Влажность ниже 50% тормозит процессы размножения, увеличивая период восстановления на 1,5–2 раза.
Кислородный режим играет ключевую роль: уровень растворенного кислорода должен поддерживаться в пределах 6–8 мг/л. При его снижении ниже 4 мг/л наблюдается значительное замедление роста колоний.
Регулярное аэрационное перемешивание среды, не реже одного раза в 2 часа, предотвращает застой и способствует равномерному распределению питательных веществ, что ускоряет восстановление бактериальной активности.
Питательные компоненты в среде должны содержать не менее 0,2% аминокислот и 0,1% углеводов, чтобы обеспечить быстрый старт биохимических процессов и деление клеток.
Избегайте резких перепадов температуры и влажности, так как стрессовые условия снижают жизнеспособность бактерий на 15–25%.
Частые ошибки при запуске Биозоны после отключения и способы их избежать

Ошибка 1: преждевременный запуск оборудования без учета полной регенерации микрофлоры. Восстановление оптимального баланса бактерий требует минимум 48 часов стабильных условий после подачи питания. Запуск до этого срока снижает эффективность биологической очистки и приводит к накоплению органики.
Рекомендация: После отключения включать Биозону только после подтверждения стабилизации параметров среды – температуры, уровня кислорода и pH.
Ошибка 2: игнорирование контроля температуры среды. Температурные колебания выше 3 °C снижают активность бактерий на 30–40%, что удлиняет восстановительный период. Чрезмерный перегрев или переохлаждение ускоряет гибель колоний.
Рекомендация: Поддерживать температуру в пределах 20–25 °C, контролировать и корректировать климат внутри установки до запуска Биозоны.
Ошибка 3: отсутствие мониторинга концентрации растворенного кислорода. Бактерии Биозоны нуждаются в стабильном уровне кислорода не ниже 4 мг/л. Низкий уровень приводит к анаэробным процессам, ухудшающим очистку.
Рекомендация: Перед запуском проверить и при необходимости включить аэрацию для достижения необходимого уровня кислорода.
Ошибка 4: несвоевременная очистка и проверка оборудования. Остатки органики и загрязнения в фильтрах и трубах после отключения способствуют росту патогенной микрофлоры, подавляющей полезные бактерии.
Рекомендация: Выполнить полную санитарную обработку и механическую очистку всех компонентов перед включением системы.
Ошибка 5: неправильное дозирование питательных добавок и биоактиваторов. Их недостаток замедляет размножение бактерий, избыток – нарушает химический баланс среды и снижает биологическую активность.
Рекомендация: Использовать только рекомендованные производителем концентрации, строго следовать регламенту по внесению добавок.
Вопрос-ответ:
Как быстро восстанавливается микрофлора в Биозоне после временного отключения системы?
Скорость восстановления бактерий зависит от продолжительности отключения и условий среды. Обычно после кратковременного перерыва активность бактерий возвращается в течение нескольких часов до суток. При более длительном отключении процесс может занять несколько дней, так как необходимо восстановить оптимальные параметры среды и активность жизнедеятельности микроорганизмов.
Что влияет на скорость восстановления бактериального сообщества в Биозоне после отключения?
На скорость восстановления влияют несколько факторов: температура и влажность внутри Биозоны, наличие питательных веществ, уровень кислорода, а также исходное состояние микрофлоры до отключения. Если условия сохраняются близкими к оптимальным, бактерии начинают активизироваться быстрее. При ухудшении параметров среды, например, при снижении температуры, процесс восстановления замедляется.
Можно ли использовать Биозону сразу после включения, если она была отключена на длительное время?
Рекомендуется дать системе время для восстановления микрофлоры, особенно если отключение длилось несколько суток. В течение этого периода бактерии восстанавливают численность и активность, что важно для поддержания нужного микроклимата и биологических процессов. Использование Биозоны сразу после включения без адаптационного периода может привести к снижению эффективности работы системы и ухудшению качества среды внутри.
Какие меры можно принять для ускорения восстановления бактерий в Биозоне после отключения?
Для ускорения процесса восстановления можно контролировать и поддерживать оптимальные параметры среды: поддерживать стабильную температуру, обеспечивать доступ кислорода, своевременно вносить питательные вещества и избегать резких перепадов влажности. Иногда применяют введение специальных бактериальных культур или активаторов, чтобы восстановить баланс микрофлоры быстрее. Важно также следить за чистотой и состоянием оборудования, чтобы исключить дополнительные стресс-факторы для бактерий.
